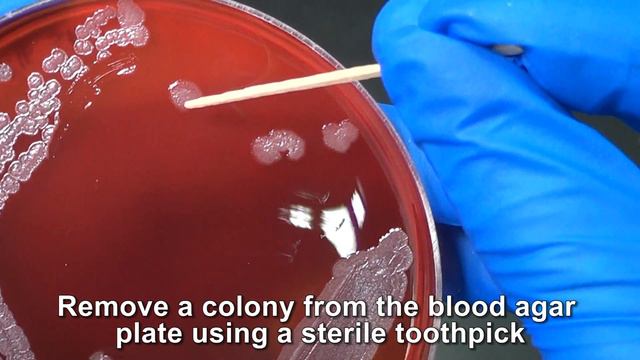
Oxidase Test смотреть онлайн

Автор: Радостный путь Страница 3

почувствуй дуновение природы,мой дорогой уставший друг🌝🔥

потоп Новокузнецкая

Kaspersky Password Manager v5.0.0.183 Final

Günümüzde çok eşlilik mümkün mü? - Ömer Döngeloğlu

Технологии делового взаимодействия и управление карьерой (7.11.2022)

Команды на командный блок

Драки не будет (про отмены концертов)

АУФ ОТТЯЖКА XIGHTLITE

High Level Hostel | Хостел в НЕБОСКРЁБЕ | Москва-Сити 2021

GMP EC стандарт. Лекарственные препараты. Гигиена персонала. Пункт 2.14 - 2.20.

PS4 PROBLEMAS,CODIGOS DE ERROR

Class 10 Maths | Chapter 3 | Exercise 3.1 Q1 | Pair Of Linear Equations in Two Variables | NCERT

/Что девочки делают дома одни/

Напишите комментарий как это Lada называется Я уже забыл это как десятки морда я я так думаю

Camarão na Moranga simples fàcil e ràpido #camaraonamoranga #shrimpwithpumpkin

Инструкторский отдел на занятиях
Oxidase Test

Коррекция нарощенных ногтей!!! Маникюр к юбилею!!!

How to be like Thorfinn - The Man With No Enemies (Vinland Saga)

Поразительные факты из мира недвижимости

Что такое деньги

GG WP 2ET

3 приложения, которые точно лучше Aliexpress

аниме которые точно надо посмотреть
За каждым успешным каналом стоит личность, идея и сотни часов кропотливого труда. Если вы здесь, значит, автор «Радостный путь» уже сумел зацепить ваше внимание своим уникальным стилем или подачей. А мы на RUVIDEO позаботились о том, чтобы вы могли изучить весь архив его работ в максимально комфортных условиях — без лишней суеты и преград.
Почему за работами канала «Радостный путь» так интересно наблюдать? Всё просто: это честный контент, который находит отклик в сердцах зрителей. На нашем ресурсе вы можете смотреть онлайн все видео любимого автора бесплатно и в хорошем качестве. Нам важно, чтобы вы видели каждую деталь и слышали каждый нюанс, поэтому мы используем только стабильные плееры из открытых источников Rutube.
Следите за новинками канала, пересматривайте старые шедевры и открывайте для себя новые грани творчества «Радостный путь». Мы постоянно обновляем ленту, чтобы у вас под рукой всегда были самые свежие выпуски. Никаких сложных регистраций — только вы и творчество, которое вдохновляет. Приятного вам путешествия по миру авторского контента на RUVIDEO!
Видео взято из открытых источников Rutube. Если вы правообладатель, обратитесь к первоисточнику.